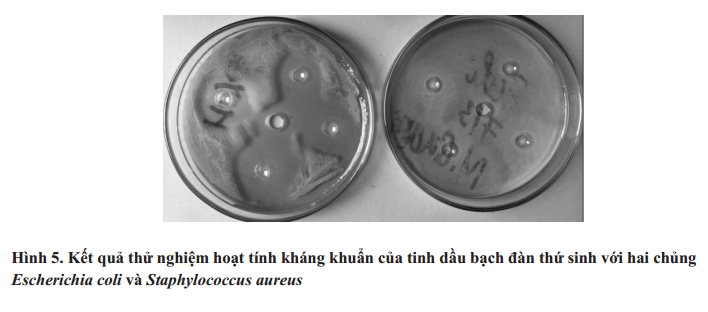
Thử nghiệm hoạt tính kháng khuẩn 1

Phùng Thị Lan Hương và Nguyễn Thị Định
Tạp chí Khoa học và Công nghệ – Vol. 18, No. 1 (2020): 54-61
Mục lục
Tóm tắt
Cây bạch đàn có tên khoa học là Eucalyptus, trồng ở nhiều vùng khác nhau tại tỉnh Phú Thọ và được biết đến nhiều thập kỷ bởi có giá trị cao về kinh tế và dược lý.
Mục tiêu của nghiên cứu là xác định thành phần hóa học và khả năng kháng khuẩn của tinh dầu bạch đàn thứ sinh được trồng tại Việt Trì, tỉnh Phú Thọ.
Bằng phương pháp GC-MS đã xác định được có 23 hợp chất được nhận diện trong tinh dầu từ lá bạch đàn thứ sinh, chiếm tỷ lệ 99,52%. Thành phần chính là 1,8-cineole (38,34%), α-pinene (18,86%), α-Terpinyl acetate (9,00%). Tinh dầu từ lá bạch đàn thứ sinh có thể hiện hoạt tính kháng khuẩn đối với hai loài Escherichia colivà Staphylococcus aureus.
Đặt vấn đề
Cây bạch đàn, còn gọi là cây khuynh diệp, tên khoa học Eucalyptus, thuộc họ Sim Myrtaceae. Tên bạch đàn là tên có từ lâu ở vùng Nghệ An, Hà Tĩnh, tên Khuynh diệp là do mùi tinh dầu có mùi tinh dầu tràm. Hiện nay tên bạch đàn được dùng phổ biến hơn ở Việt Nam với số lượng khoảng trên 20 loài [1, 2].
Trong sản xuất, bạch đàn được trồng với diện tích lớn chủ yếu bởi khả năng cung cấp gỗ. Do có khả năng tái sinh cao, nên trong quá trình sản xuất bạch đàn người dân thường khai thác bạch đàn tái sinh ít nhất một chu kỳ để tiết kiệm chi phí đầu tư. Tuy nhiên, việc tái sinh chồi thường cho năng suất gỗ giảm dần sau mỗi lần khai thác rừng chồi bạch đàn.Bên cạnh đó, lá bạch đàn khi rụng xuống đất thường ức chế sự phát triển của một số loại vi sinh vật và cả thực vật khác, nên làm suy giảm đa dạng sinh học, giảm khả năng mùn hóa xác thực vật.

Hình ảnh lá Bạch đàn
Tỉnh Phú Thọ hiện có 55% diện tích đất tự nhiên là rừng và đất lâm nghiệp, trong đó có trên 9.000 ha rừng trồng bạch đàn, diện tích rừng bạch đàn tái sinh là khá lớn (5.000 ha). Vì vậy, nếu có thể tận dụng được nguồn nguyên liệu lá bạch đàn thứ sinh tại tỉnh Phú Thọ để sản xuất tinh dầu sẽ làm tăng hiệu quả của quá trình sản xuất bạch đàn, hạn chế tác động xấu tới sinh thái [1].
Tinh dầu bạch đàn màu vàng nhạt, ở thể lỏng, mùi thơm vị lúc đầu mát sau đó nóng, tỷ trọng 0,910-0,930, độ sôi 168-180oC. Thành phần chủ yếu của tinh dầu là cineol hay Eucalyptol hay 1,8-cineole (60-85%) [2, 3, 4]. Các tác giả cũng khẳng định rằng do các thành phần như 1,8-cineole, p-cymene, eucamalol, limonene, linalool, α-pinene, γ-terpinene, α-terpineol, alloocimene và aromadendrene nên tinh dầu bạch đàn có hoạt tính trừ sâu hại, diệt nấm và vi sinh vật [5, 6, 7].
Thành phần và chất lượng tinh dầu bạch đàn phụ thuộc vào từng loài, khu vực trồng, khí hậu, loại đất và tuổi của lá, chế độ phân bón, đồng thời còn phụ thuộc vào phương pháp tách chiết. Hiện nay chưa có nghiên cứu
nào được công bố về thành phần hóa học và hoạt tính kháng khuẩn của tinh dầu từ lá bạch đàn thứ sinh được trồng tại tỉnh Phú Thọ.
Phương pháp nghiên cứu
Hóa chất và thiết bị nghiên cứu
- Hóa chất: Dung môi được sử dụng gồm: Nước cất, NaCl, NaOH, HCl, Na2SO4
- Thiết bị nghiên cứu liên quan
- Chủng vi sinh vật Escherichia coli và Staphylococcus aureus
Chế tạo tinh dầu lá bạch đàn
Chuẩn bị nguyên liệu:
Nguyên liệu được sử dụng trong nghiên cứu là lá cây bạch đàn thứ sinh được thu hái tại khuôn viên Trường Đại học Hùng Vương, thành phố Việt Trì, tỉnh Phú Thọ. Nguyên liệu được để héo trong vòng 3 ngày trong bóng râm sau đó xay nhỏ bằng máy xay.
- Chiết tách tinh dầu:
Nguyên liệu chuẩn bị xong được cho vào nồi chưng cất lôi cuốn hơi nước, khối lượng nguyên liệu sử dụng là 60kg lá bạch đàn thứ sinh đã được xay nhỏ. Quy trình chiết tách tinh dầu từ lá bạch đàn thứ sinh được tiến hành như Hình 1:

Hình 1. Quy trình chiết tách tinh dầu từ lá bạch đàn thứ sinh
Tinh dầu sau đó được tách nước bằng muối Na2SO4 khan, và đựng vào lọ thủy tinh tối màu, lưu trữ ở nhiệt độ thường sau đó đem xác định chỉ số lý hóa, xác định thành phần hóa học và khả năng kháng khuẩn.
Kết quả nghiên cứu và thảo luận
Chưng cất tinh dầu
Chưng cất tinh dầu từ lá bạch đàn thứ sinh bằng phương pháp chưng cất hơi nước tiến hành trong 3 giờ. Hàm lượng tinh dầu trong lá bạch đàn thứ sinh được tính theo công thức:

Hình 2. Hàm lượng tinh dầu trong lá bạch đàn
Thành phần hóa học
Mẫu tinh dầu được phân tích bằng phương pháp sắc ký khí nối ghép khối phổ và detector ion hóa ngọn lửa tại Viện Hóa học các Hợp chất thiên nhiên – Viện Hàn lâm Khoa học và Công nghệ Việt Nam. Kết quả thu được như sau (xem Hình 3 và Bảng 2):


Nhận xét:
Kết quả phân tích GC-MS cho thấy tinh dầu từ lá bạch đàn thứ sinh thu hái tại Việt Trì, Phú Thọ có 23 chất được nhận diện, tổng hàm lượng là 99,52% với thành phần chính là 1,8-cineole (38,34%), α-pinene (18,86%),
α-Terpinyl acetate (9,00%).
- Chất có hàm lượng cao nhất là 1,8-cineole chiếm tới 38,34%, đây là hợp chất chính và được coi như là chất đặc trưng cho tinh dầu bạch đàn trắng.
- So sánh với nghiên cứu của tác giả Nguyễn Thị Hằng xác định thành phần hóa học trong tinh dầu lá bạch đàn trắng trồng tại Xuân Mai, huyện Chương Mỹ, thành phố Hà Nội bằng phương pháp chưng cất lôi cuốn hơi nước, tỷ lệ phần trăm của hợp chất này là 32,6% [1], cho thấy thành phần hóa học của tinh dầu lá bạch đàn không những phụ thuộc vào loài, mà còn phụ thuộc vào vị trí trồng, độ tuổi của lá.

Hình 4. Hai hợp chất chính trong tinh dầu lá bạch đàn thứ sinh
1,8-cineole (38,34%), α-pinene (18,86%) là hai hợp chất có dược lý mạnh, có ứng dụng lớn trong y học, tính kháng khuẩn, kháng nấm cao, sử dụng nhiều trong mỹ phẩm, hàm lượng hai chất này càng cao, tinh dầu có giá trị càng cao…
- Đặc biệt là 1,8-cineole có nhiều các hoạt tính có tác dụng làm sạch môi trường như diệt khuẩn, diệt ký sinh trùng, kháng sinh… với những đặc tính trên, hiện 1,8-cineole đang được sử dụng là thuốc trị bệnh với chỉ định sát trùng đường hô hấp, trị ho, trị sốt.
- Ngoài ra tinh dầu bạch đàn còn được dùng trong ngành công nghiệp chất dẻo, công nghiệp quốc phòng, làm nguyên liệu để bán tổng hợp các hương liệu quý…
Thử nghiệm hoạt tính kháng khuẩn
Nhận xét:
Nhận xét:
Hoạt tính kháng khuẩn của tinh dầu lá bạch đàn thứ sinh được khảo sát bằng phương pháp Kirby-Bauer (Bauer et al., 1966). Kết quả cho thấy tinh dầu lá bạch đàn thứ sinh có hoạt tính kháng Escherichia coli và Staphylococcus aureus thể hiện qua sự xuất hiện vòng vô khuẩn xung quanh khoanh thạch có chứa tinh dầu.
- Sự xuất hiện vòng vô khuẩn xung quanh khoanh thạch có chứa tinh dầu có thể do các chất có hoạt tính kháng khuẩn trong tinh dầu đã ức chế sự phát triển của vi khuẩn.
- Điều này lý giải việc sử dụng lá bạch đàn thứ sinh như một vị thuốc dân gian để chữa một số bệnh như: chữa ghẻ lở, viêm tai, chữa bệnh lị…
Hoạt tính kháng khuẩn của tinh dầu bạch đàn thứ sinh là do sự hiện diện của một số phenol, terpen và aldoketones có trọng lượng phân tử thấp. Mỗi loại tinh dầu đều chứa các thành phần kháng khuẩn, khả năng kháng khuẩn là không tương đồng trên các chủng khác nhau.
Kết luận
- Chiết tách thành công tinh dầu từ lá bạch đàn thứ sinh được trồng tại tỉnh Phú Thọ, bằng phương pháp chưng cất lôi cuốn hơi nước với hiệu suất 0,262% trên khối lượng lá bạch đàn tươi.
- Thành phần hóa học tinh dầu từ lá bạch đàn thứ sinh trồng tại Việt Trì, Phú Thọ có 23 chất được nhận diện, tổng hàm lượng là 99,52% với thành phần chính là 1,8-cineole (38,34%), α-pinene (18,86%), α-Terpinyl acetate (9,00%).
- Tinh dầu lá bạch đàn thứ sinh có hoạt tính kháng khuẩn Escherichia colivà Staphylococcus aureus.
- Từ những giá trị kinh tế và dược lý tinh dầu bạch đàn thứ sinh đem lại, việc sản xuất tinh dầu từ lá bạch đàn thứ sinh có thể trở thành một hướng đi nhằm phát triển kinh tế tại tỉnh Phú Thọ.
